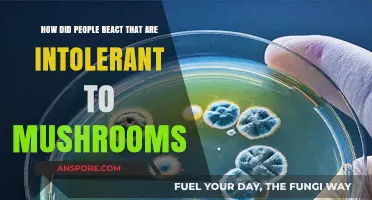
Mushroom Intolerance: People's Reactions and Stories

Dehydrating mushrooms is a great way to preserve their flavour and use them in soups, sauces, and pasta. The process of drying mushrooms in an oven is simple and requires only a few tools. However, it is important to note that the oven temperature must be kept low to prevent the mushrooms from cooking. Additionally, the mushrooms should be sliced into similar-sized pieces and thoroughly cleaned before drying. The drying process can take several hours, and the mushrooms should be flipped periodically to ensure even dehydration. Once completely dry, the mushrooms can be stored in airtight containers for up to a year.
| Characteristics | Values |
|---|---|
| Oven temperature | 125ºF/52ºC, 130ºF/54ºC, 150 F (65 C), 170 F, 230–250°C |
| Time | 2-3 hours, 4-8 hours, 4-12 hours, 1 hour, 2 hours |
| Airflow | Prop open the oven door with a wooden spoon or potholder |
| Pre-drying | Clean and slice mushrooms, removing excess water |
| Storage | Airtight container, covered glass jars |
| Rehydration | Place in a heat-proof bowl and cover with boiling water for 20-30 minutes |
Explore related products
What You'll Learn
- Cleaning mushrooms: Wash thoroughly, scrub gently, and dry before placing in the oven
- Slicing mushrooms: Cut into similar-sized pieces, 1/8- to 1/4-inch thick
- Oven temperature: Preheat to 150-170°F (65°C)
- Baking time: Bake for 1 hour, then flip and bake for another hour
- Storage: Store dried mushrooms in an airtight container for up to 3 months

Cleaning mushrooms: Wash thoroughly, scrub gently, and dry before placing in the oven
Before you dehydrate mushrooms, it's important to clean them thoroughly. Mushrooms often have dirt trapped in their crevices, so it's crucial to wash them well. Don't worry about the mushrooms soaking up water—this is just a myth. Simply hold them under running cool water and scrub them gently with a vegetable or mushroom brush to dislodge any dirt. You can also use a kitchen towel to brush off any remaining grit.
Once your mushrooms are clean, it's time to dry them. Start by slicing the mushrooms into pieces of uniform thickness, ideally about 1/4 inch thick. Thicker slices will take longer to dehydrate properly. After slicing, spread the mushrooms on a clean dish towel and gently roll it up, squeezing lightly to remove any excess surface moisture. This step is crucial because if the mushrooms are too wet, they will steam in the oven instead of drying properly.
Next, arrange the mushroom slices on a baking sheet, ensuring that none of the pieces overlap or touch. This arrangement allows for even drying and prevents moisture retention, which can affect food safety. Now, preheat your oven to a low temperature, ideally between 110°F and 150°F (65°C). If your oven has a dehydrator setting, you can use that, but keep an eye on the temperature to ensure it stays below 150°F.
Place the baking sheet with the mushrooms in the preheated oven and leave them to dry for about an hour. Then, take the mushrooms out, turn them over, and return them to the oven for another hour. For thicker slices, you may need to repeat this step until the mushrooms are fully dehydrated. You'll know they're done when they break in half instead of bending.
Medicinal Mushrooms: Nature's Superfood Supplements?
You may want to see also

Slicing mushrooms: Cut into similar-sized pieces, 1/8- to 1/4-inch thick
To dehydrate mushrooms in the oven, it is important to cut them into similar-sized pieces. This ensures that they dry evenly and thoroughly. Aim for slices that are 1/8 to 1/4 inch thick. Thinner slices will dry faster, while thicker slices may require a longer drying time. It is also crucial to remove any excess moisture from the mushroom surfaces before placing them in the oven. Blot the mushrooms with a paper towel or gently squeeze them in a clean dish towel to eliminate surface moisture.
When slicing mushrooms for dehydration, it is recommended to use a sharp knife and cut them into uniform pieces. This helps in achieving the desired slice thickness and also speeds up the drying process. Make sure your hands and the knife are clean to avoid any contamination. Wash the mushrooms thoroughly before slicing to remove any dirt or debris. You can also use a vegetable or mushroom brush to gently scrub them under running cool water.
Another important tip when slicing mushrooms for dehydration is to work in small batches. This helps ensure that the mushrooms remain fresh and reduces the risk of discolouration. It also makes it easier to cut them into similar sizes. Once sliced, it is advisable to spread the mushrooms on a baking sheet in a single layer, leaving some space between them for proper air circulation.
Additionally, it is worth mentioning that the drying time may vary depending on the thickness of the slices and the humidity levels in your oven. Thicker slices may require a longer drying time, and it's important to check on them periodically to ensure they don't over-dry or burn. Adjust the drying time as needed based on the thickness of your mushroom slices.
Finally, once the mushrooms are dehydrated, let them cool completely before storing them. Proper cooling helps ensure that any remaining moisture evaporates, and it also prevents condensation from forming when they are stored in airtight containers. You can store dried mushrooms in covered glass jars or airtight containers and keep them away from direct light and heat.
Mushrooms: Carb-Friendly or Carb-Heavy?
You may want to see also

Oven temperature: Preheat to 150-170°F (65°C)
Drying mushrooms in the oven is a great way to preserve their flavour and use them in soups, sauces, and pasta. The oven temperature plays a crucial role in achieving the desired dehydrated texture without cooking the mushrooms.
To dehydrate mushrooms in the oven effectively, preheating to a temperature range of 150-170°F (65°C) is recommended. This temperature setting strikes a balance between gentle heat and airflow, gradually removing moisture from the mushrooms. At higher temperatures, mushrooms can 'case harden', where the outer layer cooks, trapping moisture inside.
When using a convection oven, setting the temperature at 170°F with the door slightly ajar can help maintain temperatures below 150°F. This technique ensures adequate airflow and prevents overheating.
It's important to remember that thicker mushroom slices will take longer to dehydrate, so consider the size of the pieces and the oven temperature accordingly. The dehydration process can be monitored by checking the mushrooms' texture; they should snap rather than bend when adequately dry.
By preheating the oven within the suggested temperature range and adjusting for thickness and airflow, you can successfully dehydrate mushrooms and take advantage of their enhanced flavour and year-long shelf life.
Shiitake Mushrooms: A Psychedelic Trip?
You may want to see also
Explore related products

Baking time: Bake for 1 hour, then flip and bake for another hour
Drying mushrooms in the oven is a great way to preserve their flavour and use them in soups, sauces, and pasta. The oven-dried mushrooms can be stored in airtight containers for up to three months.
To begin the dehydration process, the mushrooms must be cleaned thoroughly under running cool water. Use a vegetable or mushroom brush to scrub away any dirt. Next, slice the mushrooms into pieces of similar size, preferably 1/8 to 1/4 inch thick. Thicker slices will take longer to dry.
Before placing the mushrooms in the oven, it is crucial to remove any surface moisture. Spread the sliced mushrooms on a clean dish towel and gently roll it up. Squeeze gently to absorb any excess water. Then, arrange the mushrooms on a baking sheet, ensuring they do not overlap or touch each other. Blot the mushrooms with a paper towel to remove any remaining moisture and prevent steaming in the oven.
Preheat the oven to a low temperature, ideally between 130ºF/54ºC and 150 F (65 C). Some sources suggest a temperature of 170 degrees Fahrenheit. Place the baking sheet with the mushrooms in the oven and leave them for about one hour. After an hour, remove the mushrooms from the oven and flip them over. Return the mushrooms to the oven and bake for another hour.
Check the mushrooms after the second hour. They should be completely dry and crisp. If they are not, you can continue drying them in the oven. Flip the mushrooms again and bake for another 30 minutes. Keep checking their dryness every half hour and repeat the process until they are fully dehydrated. The mushrooms are ready when they snap instead of bending and have a brittle texture.
Mushroom Mycelium: Nature's Superfood for Health?
You may want to see also

Storage: Store dried mushrooms in an airtight container for up to 3 months
Dried mushrooms can be stored for at least a year, and when you rehydrate them, their texture is almost identical to fresh mushrooms. However, it's important to note that the potency of psilocybin-containing products may gradually decline over time.
To store dried mushrooms, make sure they are completely dry and have cooled down before transferring them to airtight containers. Glass jars are a good option for storing dried mushrooms, as they can be sealed tightly with lids to prevent moisture from getting in. It is also recommended to label the jars with the variety of mushroom and the date they were dried.
Store the jars away from direct light, heat, and contaminants. The ideal storage temperature for dried mushrooms is cool, and they should not be exposed to freezing temperatures or sunlight. Additionally, avoid exposing dried mushrooms to oxygen as it can lead to oxidation and degradation.
With proper storage, dried mushrooms can last for up to a year or even longer. However, it is recommended to consume them within three months for optimal quality and potency.
Mushrooms: Why Do They Turn Black?
You may want to see also
Frequently asked questions
The best way to dehydrate mushrooms is to use a dehydrator. However, you can get good results using your oven.
Clean the mushrooms well by scrubbing gently with a vegetable or mushroom brush. Slice the mushrooms to a thickness of 1/8 to 1/4 inch. Thicker slices will take longer to dry. Make sure to remove all surface moisture by placing the sliced mushrooms on a clean dish towel and gently squeezing before arranging them on a baking sheet.
Preheat your oven to a low temperature of around 150°F (65°C) to 170°F.
Place the baking sheet with the mushrooms in the oven and leave for one hour. Then, turn the mushroom slices over and return them to the oven for another hour. Take them out and let them cool before checking if they are crispy dry. If not, return them to the oven for another 30 minutes.